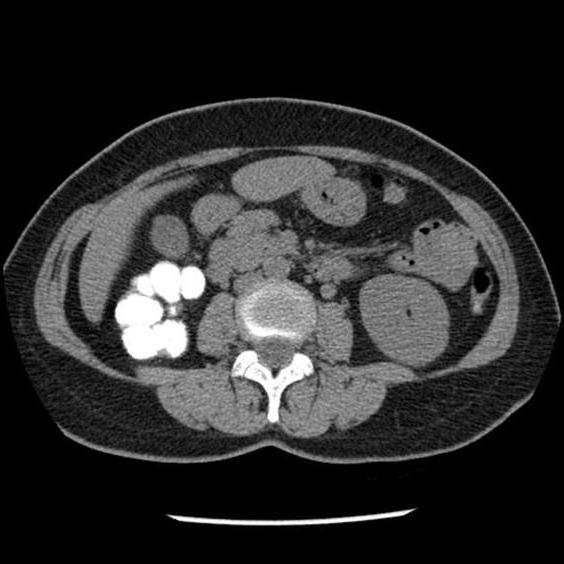
image

Внелегочный туберкулез — термин, под которым объединяют целую группу заболеваний, поражающих разные системы органов, начиная от кожи и костей и заканчивая нервной системой и лимфатическими узлами. Эти патологии опасны в первую очередь потому, что диагностируются слишком поздно, уже на этапе развития осложнений.
Естественно, многие люди интересуются подробной информацией о подобных заболеваниях. Заразен ли внелегочный туберкулез? Какие системы органов может поражать инфекция? Какими симптомами сопровождается недуг? Ответы на эти вопросы будут полезны многим читателям.
Внелегочные туберкулезные поражения и их причины
Внелегочный туберкулез — инфекционное заболевание, связанное с проникновением в организм человека микобактерий. Они могут поражать разные системы органов, включая скелет, кишечник, желудок, кожу, глаза, почки и т. д. Согласно статистическим исследованиям, внелегочные формы, как правило, являются вторичными заболеваниями и развиваются на фоне активно протекающего легочного туберкулеза. Тем не менее изредка у пациентов диагностируются исключительно внелегочные очаги поражения.
Если говорить об инфицировании человеческого организма, то примерно в 90% в роли возбудителя выступает Mycobacterium tuberculosis (палочка Коха). Гораздо реже туберкулез развивается на фоне внедрения и активного размножения Mycobacterium bovis — эта бактерия, кстати, может поражать и представителей крупного рогатого скота. В тропических странах распространен иной штамм возбудителя – M.africanum.
Стоит сказать, что это чрезвычайно устойчивые микроорганизмы. В воде они способны сохранять способность к жизнедеятельности до пяти месяцев. В кипящей воде микобактерии выживают 5-45 минут. С другой стороны, возбудители туберкулеза чрезвычайно чувствительны к ультрафиолетовому излучению.
Можно ли заразиться внелегочным туберкулезом?
Безусловно, туберкулез внелегочной локализации, равно как и легочная форма заболевания, передается от больного человека к здоровому. Возбудитель выделяется во внешнюю среду вместе со слизью во время кашля, чихания и т. д. Поэтому в группе повышенной опасности находятся люди, которые живут и тесно общаются с больными туберкулезом.
Но все не так просто. Многие люди даже после не одного десятка лет жизни под одной крышей с пациентом не являются инфицированными. Более того, инфицирование еще не значит болезнь. Считается, что практически треть населения планеты — носители палочки Коха. Тем не менее далеко не все из них действительно страдают от туберкулеза.
Носители инфекции не являются заразными и могут жить, даже не подозревая о наличии инфекции. Тем не менее риск развития заболевания имеется. Активация микобактерий происходит на фоне сильного снижения иммунитета, поэтому к факторам риска относят затяжные заболевания, хронические воспалительные недуги, которые попросту истощают организм, а также частые стрессы, физическое перенапряжение, гормональные нарушения, неправильное питание, словом, все, что может сказаться на работе иммунной системы.
Классификация и формы заболевания
Существует несколько систем классификации данных патологий. Например, по распространенности выделяют следующие внелегочные формы туберкулеза:
Во время диагностики обращают внимание и на степень активности заболевания:
- активные формы заболевания (прогрессирующие, рецидивирующие, затихающие);
- неактивные внелегочные формы туберкулеза (у пациента сохраняются специфические изменения органов, характерные для туберкулеза, возможно наличие мелких очагов, абсцессов или рубцов, но лабораторные анализы демонстрируют отсутствие дальнейших изменений).
Для процесса диагностики важно и наличие осложнений. Они могут быть общими (например, вторичных иммунодефицит, токсические и аллергические поражения органов, амилоидоз, патологии системного значения) и местными (непосредственно связаны с пораженным органом или системой).
Туберкулез костей и суставов
Внелегочный туберкулез суставов и костей — сравнительно распространенное хроническое заболевание, которое сопровождается поражениями разных участков двигательного аппарата. На фоне активности патогенных микроорганизмов наблюдается образование специфической гранулемы, а также прогрессирующее разрушение костных тканей, что, естественно, влечет за собой не только анатомические, но и функциональные изменения скелета.
Согласно статистике, большая часть пациентов с этим диагнозом — люди пожилого возраста. Примерно в 60% случаев болезнь поражает позвоночник, что ведет к инвалидности. Гониты, спондилиты и кокситы — это самые распространенные нарушения, которыми сопровождается внелегочный туберкулез. Симптомы практически не проявляются на ранних стадиях заболевания.
Иногда пациенты отмечают болезненность в области пораженной части опорно-двигательного аппарата. Если недуг развивается по типу артрита, то можно отметить дискомфорт, припухлость в мелких суставах, ограниченность движений. Если речь идет о поражении позвоночника, то растущая гранулема нередко сдавливает нервные корешки, что сопровождается различными неврологическими расстройствами.
К признакам можно отнести постепенные изменения осанки. Мышцы начинают терять тонус, из-за чего человеку трудно двигаться.
К сожалению, люди обращаются к врачу на поздних стадиях, когда уже присутствуют такие осложнения внелегочного туберкулеза, как абсцессы, стойкие деформации скелета, свищи. Диагностика заболевания может быть сопряжена с некоторыми трудностями, так как клиническая картина здесь весьма смазана. В большинстве случаев даже после грамотно проведенного лечения деформации костей остаются.
Поражения нервной системы
Внелегочный туберкулез мозговых оболочек считается наиболее тяжелой формой заболевания. Недуг развивается стремительно и при отсутствии лечения ведет к необратимым нарушениям в работе нервной системы, а иногда и к смерти. Правда, на сегодняшний день случаи данного заболевания регистрируются редко.
В свое время наиболее часто диагностировался подобный внелегочный туберкулез у детей. Уменьшение распространения недуга связывают с массовым проведением прививки БЦЖ среди новорожденных. Это теория подтверждает фактом, что на сегодняшний день туберкулезный менингит регистрируется среди детей без вакцинации.
Краткосрочные приступы головной боли, незначительное повышение температуры, слабость и общее недомогание — именно так начинается внелегочный туберкулез. Симптомы появляются по мере развития менингита. Головная боль появляется чаще и становится более интенсивной. Температура тела поднимается до 39-40 градусов. Повышается возбудимость, развивается чувствительность к свету. Характерным признаком является появление анорексии и резкая потеря веса. При отсутствии лечения на 3-5 неделе наступает смерть пациента, которая связана с параличом дыхательного или сосудодвигательного центра головного мозга.
Абдоминальный туберкулез
Стоит отметить, что абдоминальные поражения встречаются редко и составляют всего 2-3% от всех случаев внелегочного туберкулеза. Как правило, сначала патологический процесс охватывает лимфатические узлы забрюшинноого пространства и брыжейки и только после этого туберкулезные поражения распространяются на органы брюшной полости.
Стоит сказать, что иногда недуг может переходить на пищевод. В таких случаях наблюдается постепенное изъязвление стенок пищеводной трубки, ее сужение вплоть до полного стеноза. Примерно такая же картина наблюдается и при поражении желудка — в пилорическом отделе и в области большой кривизны образовываются небольшие, но множественные неболезненные язвы.
Поражение кишечника может переходить на ткани червеобразного отростка. Иногда у пациентов диагностируется и туберкулез тонкого кишечника. К сожалению, выявление внелегочного туберкулеза в данном случае является трудным процессом. Симптомы заболевания не слишком выражены, а клиническая картина нередко напоминает хронические энтериты, аппендициты и прочие заболевания органов пищеварительной системы.
К опасным формам туберкулеза относится мезаденит. При подобном недуге поражаются лимфатические сосуды брюшины, но процесс постепенно переходит на матку и яичники. Фиброзный воспалительный процесс органов репродуктивной системы становится причиной бесплодия у пациенток.
Туберкулезные поражения кожи
Палочка Коха часто локализуется в кожных и подкожных тканях, вызывая самые разные заболевания.
- Туберкулезный шанкр — представляет собой уплотненное образование, внутри которого происходят гнойные процессы. Как правило, подобные структуры образуются в области лимфатического узла. Гнойники нередко вскрываются, оставляя после себя свищи.
- Туберкулезная волчанка — болезнь, которая характеризуется появление специфической сыпи на коже лица. Высыпания представляют собой плотные узелки, которые постепенно сливаются между собой, образуя плотный, плоский инфильтрат. Оболочка его часто покрывается язвами или свищами.
- Колликвативный туберкулез кожи — недуг, для которого характерно образование на коже небольшого плотного узла, диаметров 1-3 см. Это безболезненная опухоль, которая вскрывается несколькими свищами.
- Бородавчатая форма туберкулеза кожи сопровождается появление на коже уплотнений, которые по форме напоминают папилломы. Тем не менее отличия есть. В частности, вокруг образования имеется воспалительный ободок, а кожа в этой зоне приобретает цианотический оттенок. Наиболее часто эта форма болезни диагностируется у пациентов с открытой формой легочного туберкулеза, поскольку на кожу во время кашля постоянно попадает мокрота. К группе риска относятся врачи, работающие с туберкулезными пациентами, а также ветеринары.
- Милиарный туберкулез сопровождается появлением мелких папулезных высыпаний розового цвета. Часто они локализуются вокруг естественных отверстий, хотя не исключено их распространение и на другие участки кожи. По мере прогрессирования болезни в центре папулы образуется небольшая язва, которая затем покрывается коркой. При отсутствии лечения зоны изъязвлений становятся очагами некроза.
Вне зависимости от формы, кожный туберкулез характеризуется вялым течением без выраженного воспалительного процесса или болезненности. Периоды ремиссии сменяются обострениями, которые, как правило, припадают на весеннее и осеннее время.
Урогенитальный туберкулез
Если речь идет о таком заболевании, как внелегочный туберкулез, то примерно в 37% случаев инфекция поражает органы выделительной системы. Согласно статистике, у мужчин инфекция распространяется и на половую систему, в то время как среди женщин подобные случаи встречаются гораздо реже.
Чаще всего от заболевания страдают почки. Клиническая картина весьма нечеткая. Сначала симптомы и вовсе не проявляются. По мере развития недуга могут появляться несильные, ноющие боли в пояснице. Часто туберкулез почек диагностирую случайно, во время полного анализа мочи, обнаруживая в образцах микоплазму.
Если не оказать пациенту необходимую медицинскую помощь, есть риск развития фиброза и гидронефроза.
В тех случаях, когда инфекция распространяется на органы половой системы, у мужчин в первую очередь поражается предстательная железа. Далее развиваются осложнения в виде инфицирования яичек, семявыносящих протоков и семенных канатиков.
Туберкулез лимфатических узлов
Наиболее распространенной формой является внеклеточный туберкулез, который поражает периферические лимфатические узлы. Согласно статистике, на его долю припадает около 50% всех случаев внеклеточных форм разновидностей недуга. Более того, как правило, он сочетается с поражением легких и других органов грудной клетки.
В современной медицине чаще регистрируются случаи локального туберкулезного лимфаденита. Инфекция поражает лишь одну группу лимфоузлов, причем чаще всего страдают шейные и подчелюстные. Реже инфекция проникает в паховые и подмышечные лимфатические узлы. Кроме того, возможны и генерализованные формы недуга, при которых поражено более трех групп лимфоузлов одновременно.
Признаки внелегочного туберкулеза в данном случае не слишком выражены. На начальных стадиях наблюдается увеличение лимфатических узлов. Они эластичные, мягкие на ощупь, подвижные и поначалу безболезненные. Изменение их размеров никак не связано с простудами или заболеваниями лор-органов.
Характерным признаком именно туберкулезной формы лимфаденита является вовлеченность в патологический процесс окружающих мягких тканей, а по мере развития болезни – и соседних лимфатических узлов. Так образуются довольно крупные припухлости. В дальнейшем в центре опухоли появляется участок размягчения. На этом этапе кожа над пораженными углами истончается, иногда приобретает красный или синюшный оттенок.
При отсутствии лечения происходит разрыв тканей, в результате чего образуется свищ, сквозь который наружу выходит содержимое творожистой консистенции. Ткани покрываются язвами, возможны кровотечения. Свищ может срастаться, причем на поверхности его образуются грубые рубцы. К сожалению, заживление тканей не длится долго — наступает рецидив, в результате которого свищ снова открывается.
В некоторых случаях наблюдается генерализация патологического процесса, поражаются другие группы лимфатических узлов. К таким опасным последствия приводит внелегочный туберкулез. Диагностика в этом случае проводится путем биопсии с дальнейшим лабораторным исследованием полученных образцов.
Как диагностировать внелегочный туберкулез?
Как можно увидеть, существует огромное количество симптомов и осложнений, к развитию которых приводят внелегочные формы туберкулеза. Диагностика подобных недугов, к сожалению, сопряжена с некоторыми трудностями, так как распознать клиническую картину удается далеко не в каждом случае. Более того, большинству пациентов ставят диагноз уже на запущенных стадиях туберкулеза.
Естественно, для выявления заболевания необходимо провести ряд исследований. В первую очередь это проба Манту с применением разных доз туберкулина. Такой тест помогает определить, относится ли пациент к группе риска. Кроме того, важным этапом диагностики является рентгенография и флюорография, поскольку внелегочные формы недуга, как правило, развиваются на фоне туберкулеза легких. Даже незначительные, остаточные поражения легких могут подтвердить наличие у пациента инфекционных осложнений в тех или иных органах.
В дальнейшем проводятся и дополнительные исследования, в частности, УЗИ, магнитно-резонансная и компьютерная томография, биопсия и лабораторное исследование тканей на наличие возбудителя туберкулеза.
Лечение внелегочного туберкулеза и его особенности
Безусловно, это опасный диагноз, а потому в первую очередь пациенты интересуются наличием эффективным терапевтических процедур. Лечение внелегочного туберкулеза — процесс длительный и комплексный, а его основные этапы совпадают со схемой терапии при легочных формах недуга.
К сожалению, антибактериальная терапия срабатывает редко. Дело в том, что микобактерии быстро вырабатывают устойчивость практически ко всем разновидностям антибиотиков, поэтому подобные препараты, как правило, применяются в качестве вспомогательных средств.
Наиболее эффективной считается химиотерапия. На сегодняшний день существует несколько схем подобного лечения. Чаще всего проводится так называемая четырехкомпонентная терапия, которая включает в себя применение рифампицина, стрептомицина, изониазида и пиразинамида. Некоторые приватные клиники используют более прогрессивную пятикомпонентую схему, добавляя в перечень лекарств некоторые препараты нового поколения. Правильно подобранная комбинация помогает уничтожить возбудителей туберкулеза, но, к сожалению, лечение на этом не заканчивается.
Поскольку химиотерапия при туберкулезе негативно воздействует на организм, применяются различные гепатопротекторы, а также препараты, ускоряющие процесс выведения токсинов из организма (средства, содержащие ацетилцистеин, реосорбилакт). Кроме того, важной частью терапии является прием иммуностимуляторов, включая глутоксим, ксимедон, галавит.
Иногда в схему лечения включают витамины группы А в целях профилактики развития периферических нейропатий. В некоторых случаях необходимо хирургическое вмешательство. В частности, операцию назначают в случае формирования гранулем в позвоночнике, так как это единственный способ предотвратить серьезные повреждения нервных корешков и спинного мозга.
Даже после проведения всех терапевтических мероприятий есть правила, которыми должен руководствоваться больной. Важным этапом восстановления организма является здоровый образ жизни и правильная диета. Рацион должен включать в себя питательные вещества, а также весь комплекс витаминов и минералов. Важно восстановить нормальную массу тела. А еще при туберкулезе (легочном или внелегочном) обязательным является регулярное санаторно-курортное лечение.
Внелегочный туберкулез (ВЛТ) – диагноз, объединяющий туберкулёз различных форм, кроме дыхательных органов, из-за особенностей локализации заболевания, патогенеза, клинических проявлений, диагностики и лечения.
Описание
Возбудителями болезни выступают микобактерии туберкулёза: M.bovis, M.tuberculosis, M.africanum и некоторые другие. Наиболее распространены микобактерии M.tuberculosis.
В группы риска по внелегочному туберкулезу относятся:
- люди злоупотребляющие алкоголем;
- курящие;
- страдающие диабетом;
- онкобольные;
- люди с СПИДом;
- не соблюдающие правил гигиены;
- плохо питающиеся;
- страдающие от постоянных стрессов.
Все эти категории имеют большие шансы заболеть внелёгочным туберкулёзом.
Внелегочные формы туберкулеза у детей такие же, как и у взрослых, но, к счастью, если верить статистике, процент детей, болеющих этим страшным недугом уменьшается от года к году.
Легочный и внелегочный туберкулез тесно связаны между собой и наличие первого может грозить появлением второго, поэтому при малейших подозрениях следует обращаться к врачу.
Пути передачи
Туберкулез очень заразен. Находясь рядом с больным, который говорит, кашляет или чихает, вы рискуете, с большой долей вероятности, подхватить недуг. Заболевание также, может передаваться через молочные продукты, произведенные зараженными животными.
С развитием медицины клинические формы данного заболевания встречаются все реже, а при профилактике, своевременном обращении к доктору и надлежащем лечении этот процент вообще можно минимуму.
Лечение и диагностика внелегочного туберкулеза напрямую зависит от локализации инфицированных участков.
Костно-суставной туберкулёз
Наиболее частая локализация внелегочного туберкулеза — в тканях костей и суставов (более 20% всех случаев). У больного происходит поражение различных скелетных отделов (позвоночник, колени, тазобедренные суставы).
На следующей картинке вы видите части скелета, которые чаще всего поражает туберкулез:
Это заболевание распространено, в основном, у взрослых, но может быть диагностировано и у ребенка.
- Травмы;
- Перегрузки опорно-двигательного аппарата;
- Переохлаждение;
- Заболевания, имеющие повторяющийся характер;
- Неблагоприятные трудовые и/или бытовые условия.
Несмотря на свою распространенность, подобная форма внелегочного туберкулеза почти не имеет летального исхода. Однако количество людей, ставших инвалидами и потерявших трудоспособность на долгое время, превышает 50%.
- Температура (до 37С);
- Вялость и сонливость у детей;
- Раздражительность;
- Боли в мышцах;
- Возможны позвоночные боли, не имеющие определенного местоположения (обычно проходят после отдыха).
На начальных этапах заболевания наблюдаются слабовыраженные симптомы, либо же они могут вовсе отсутствовать.
При выходе туберкулёзного воспаления за пределы позвоночника наступает второй этап:
- Усиление симптомов предыдущей фазы.
- Появляются выраженные боли в одном из отделов позвоночника, что влечет за собой понижение активности больного.
- Ухудшается осанка, меняется походка.
- Снижается интенсивность боли и она полностью прекращается в состоянии покоя.
- Мышцы стабилизаторы позвоночника находятся в постоянном напряжении.
Третий этап туберкулеза позвоночника характеризуется переходом воспалительного процесса на ткани других позвонков:
- Значительная потеря веса.
- Высокая температура (39-40С).
- Невыносимые боли в позвоночнике. Снижением интенсивности в состоянии покоя.
- Атрофия мышц спины.
Чтобы выявить и начать бороться с туберкулёзом костей, необходимы:
- клинические исследования в лабораториях;
- проведение рентгенографии;
- динамические наблюдения;
- изучение, с точки зрения цитологии, гистологии и бактериологии, добытых пункцией или биопсией, образцов.
На выздоровление уйдет 1,5 − 3 лет.
Основой является комплексное лечение: хирургическое вмешательство вместе со специальной терапией антибактериальными препаратами. Можно встретить ортопедические, физические и функциональные методы лечения.
Лечение не в силах обратить следующие симптомы: деформация позвоночника, двигательная ограниченность и мышечная атрофия.
Туберкулезный лимфаденит
Подобная форма внелегочного туберкулеза расценивается как выражение общего заболевания. Её патогенез позволяет, в большинстве случаев, определять её как самостоятельное заболевание.
Поражение туберкулезный лимфаденитом подразделяется на:
- Первичное – проникновение микробактерий в лимфоузлы через поврежденные участки во рту, носу, на коже.
- Вторичное – распространение болезни из уже пораженных органов.
- Уплотнение лимфоузлов.
- Возможно расплавление капсулы лимфоузла.
- Образование кожных свищей, с белым творогоподобным содержимым.
- Температура (около 37,5°С).
- Общая слабость.
- Потеря аппетита.
- Иногда болезнь носит симптомы интоксикации.
Симптомы могут отличаться у стариков, детей и беременных женщин. Для них характерно:
- Острое начало заболевания.
- Температура 38−39°С.
- Вялость.
- Увеличенные лимфоузлы, вызывающие боль при прикосновении.
- Казеозноое перерождение и гнойное расплавление, открываются свищи.
Диагноз ставиться по принципу выявления обыкновенного туберкулёза: исследование гнойных выделений под микроскопом.
Лечение туберкулёзного лимфаденита, в отличие от других внелегочных форм туберкулеза, носит тот же характер, что и лечение гнойных ран. Особенности же этого заболевания устраняются антибиотические препаратами, применяемыми во время лечения.
Туберкулез органов мочеполовой системы
Является одним из наиболее распространенных урологических заболеваний.
Здесь все зависит от органа, который был поражен.
- Общее снижение самочувствия.
- Вялость, утомляемость.
- Потливость.
- Расстройство сна.
- Одышка.
- Тупая боль в пояснице.
- Нарушение мочеиспускания.
- Повышение артериального давления.
- Поражение мочевого пузыря:
- Учащенное мочеиспускание.
- Могут наблюдаться боли по окончании процесса мочеиспускания.
- Появление крови в моче.
Диагностика
С помощью общего анализа мочи можно засечь выросшее количественное соотношение лейкоцитов, увеличенную концентрацию эритроцитов, белка и высокий титр бактерий. Зачастую бактериологическое исследование мочи позволяет выявить палочки Коха и диагностировать болезнь.
При исследовании под микроскопом, есть шанс, что бактерии не будут обнаружены, если болезнь находится на ранней стадии. В таком случае можно использовать бактериологический метод. Его суть заключается в высевании, на питательную среду Штейна-Левенталя мочи больного. Через 14 дней в такой моче микроорганизмы образуют свои колонии и настаёт момент установления диагноза.
Также рекомендуется провести рентгеновское обследование легких и ультразвуковое обследование почек. Подобные услуги вам предоставит почти любая клиника.
Если разделить болезнь на 4 стадии, то лечение протекает следующим образом:
- I и II: используют комбинацию из химиотерапевтических и антибактериальных препаратов.
- III и IV стадии: хирургическое вмешательство, вероятно удаление почки.
Туберкулезный менингит
Заболевание возникает, когда микобактерии туберкулёза, распространяясь, добираются до мозга, что влечет за собой воспалительные процессы.
Возрастной дифференциал по данному заболеванию указывает на то, что у детей шанс заразиться намного выше, чем у взрослых. Впрочем, та же ситуация обстоит и с обыкновенным менингитом.
Периоды развития туберкулёзного менингита различны.
Продромальный – последовательное (до 56 дней) развитие:
- Тошнота.
- Лихорадка.
- Головная боль.
- Головокружение.
- Температура.
- Задержка стула и мочи.
- Раздражения – через 7-15 дней после первого периода:
- Усталость.
- Запор с отсутствием вздутия.
- Боязнь света.
- Шумобоязнь.
- Кожная гиперестезия.
- Стремительное появление и исчезновение красных пятен на лице и груди.
- Появление менингеального синдрома в течение недели после начала второго периода.
- Также может наблюдаться снижение зрения, косоглазие, различие в диаметре зрачков, паралич века глухота.
- Могут наблюдаться потеря речи и слабость в конечностях.
- Потери сознания.
Терминальный – от 2 до 3,5 недель:
- Парезы.
- Параличи.
- Потеря сознания.
- Тахикардия.
- Высокая температура (около 40С).
- Пролежни.
После проведение пункции, исследуют цереброспинальную жидкость больного. Это должно показать:
- Плеоцитоз;
- преобладание лимфоцитов;
- повышение содержания белка;
- увеличение глобулинов.
- Биохимическое исследование покажет снижение уровня глюкозы. Используется компьютерная и магниторезонансная томография.
Срочная госпитализация больного для дальнейшего исследования симптомов и установления точного диагноза. Болезнь относиться к летальным, поэтому отсутствие должного лечение приведет к смерти пациента.
Туберкулезный перитонит
Туберкулезный перитонит — самая распространенная форма воспаления брюшины или брюшной полости хронического характера.
- Нарушения аппетита.
- Слабость.
- Быстрая утомляемость.
- Головные боли.
- Перепады настроения.
- Повышенная потливость.
- Неприятные ощущения в животе.
- Нарушение стула (жидкий стул / запор).
- Может наблюдаться рвота.
- Тянущие боли в области живота.
- Ощущение вздутости живота.
- Нарушение обмена веществ (быстрое снижение веса, либо его набор).
- Эмоциональные всплески или инертность.
- Нарушение менструального цикла у женщин.
- Проходит в условиях стационара, где человеку предоставляется должный сестринский уход.
- Используется комплексная химеотерапия.
- В некоторых случаях применяется хирургическое вмешательство.
Туберкулезный перикардит
Перикардит − воспаление сердечных оболочек, носящее инфекционной либо неинфекционной характер.
Зависит от типа перикардита.
- Тупая сдавливающая боль в области сердца.
- Иногда наблюдаются нарушения кровообращения.
- Понижение артериального давления.
- Тупая сдавливающая боль, которая может переходить в область между лопаток или в угол левой лопатки.
- Одышка.
Аспирация жидкости с последующим исследованием или посевом на наличие возбудителя туберкулёза подтвердит диагноз. В случае обнаружения поражения микробактериями туберкулеза других органов вероятность, что перикард тоже поврежден, резко возрастает.
Перикардиоцентез и микродренирование перикарда (до 5 дней) и введение ПТП в его полость. Курс антибиотиков и глюкокортикоидных препаратов.
Туберкулез печени
В подавляющем большинстве случаев туберкулез печени предшествует кишечному туберкулёзу. Печень заражается при проникновении туберкулезных микробактерий гематогенным, либо лимфогенным путем.
- Анорексия.
- Общее недомогание и слабость
- Повышенная потливость, особенно ночная.
- Сонливость.
- Субфебрилитет.
- Боль в правом подреберье.
- Увеличение печени.
- Увеличение селезенки.
- эхография и сканирование;
- пункционная биопсия печени.
Лечение протекает также, как и при обыкновенном туберкулезе. Больному, в том числе назначается специальная диета (№5а / №5).
Сестринский процесс при туберкулезе – один из важнейших компонентов, так как именно от его качества может зависеть скорость выздоровления пациента. При стационарном лечении именно медсестра проводит все необходимые процедуры, назначенные доктором. Также она должна следить за состоянием здоровья больного и отслеживать какие симптомы внелегочного туберкулеза появились, а какие исчезли.
При желании сестринский процесс при туберкулезе может освоить близкий больному человек, для осуществления ухода на дому. Однако подобный выбор не рекомендуется, ибо при осложнениях и в экстренных ситуациях, квалифицированная медсестра может среагировать намного быстрее и устранить угрозу профессиональнее, чем это бы сделал не тренированный человек. В экстренных ситуациях важна каждая секунда, поэтому настоятельно рекомендуется прибегать к домашнему лечению лишь с позволения лечащего врача.
Неверная диагностика
При лечении легочного и внелегочного туберкулеза нельзя переоценить важность дифференциальной диагностики, ведь теми же симптомами обладают как незначительные отклонения в самочувствии (недомогание), так и серьезные смертельные болезни (хронический легочный аспергиллез). Поэтому со всей ответственностью к делу должен относиться как больной (вовремя обратиться к доктору, неукоснительно следовать его указаниям) так и мед персонал.